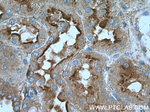
Annexin VI Antibody in Immunohistochemistry (Paraffin) (IHC (P))

Search
Proteintech
Annexin VI Polyclonal Antibody
{{$productOrderCtrl.translations['antibody.pdp.commerceCard.promotion.promotions']}}
{{$productOrderCtrl.translations['antibody.pdp.commerceCard.promotion.viewpromo']}}
{{$productOrderCtrl.translations['antibody.pdp.commerceCard.promotion.promocode']}}: {{promo.promoCode}} {{promo.promoTitle}} {{promo.promoDescription}}. {{$productOrderCtrl.translations['antibody.pdp.commerceCard.promotion.learnmore']}}
产品信息
12542-1-AP
种属反应
已发表种属
宿主/亚型
分类
类型
抗原
偶联物
形式
浓度
纯化类型
保存液
内含物
保存条件
运输条件
产品详细信息
Immunogen sequence: DDDAAGQFF PEAAQVAYQM WELSAVARVE LKGTVRPAND FNPDADAKAL RKAMKGLGTD EDTIIDIITH RSNVQRQQIR QTFKSHFGRD LMTDLKSEIS GDLARLILGL MMPPAHYDAK QLKKAMEGAG TDEKALIEIL ATRTNAEIRA INEAYKEDYH KSLEDALSSD TSGHFRRILI SLATGHREEG GENLDQARED AQVAAEILEI ADTPSGDKTS LETRFMTILC TRSYPHLRRV FQEFIKMTNY DVEHTIKKEM SGDVRDAFVA IVQSVKNKPL FFADKLYKSM KGAGTDEKTL TRIMVSRSEI DLLNIRREFI EKYDKSLHQA IEGDTSGDFL KALLALCGGE D (324-674 aa encoded by BC017046)
靶标信息
Annexin VI belongs to a family of calcium-dependent membrane and phospholipid binding proteins. Although their functions are still not clearly defined, several members of the annexin family have been implicated in membrane-related events along exocytotic and endocytotic pathways. The annexin VI gene is approximately 60 kbp long and contains 26 exons. It encodes a protein of about 68 kDa that consists of eight 68-amino acid repeats separated by linking sequences of variable lengths. It is highly similar to human annexins I and II sequences, each of which contain four such repeats. Exon 21 of annexin VI is alternatively spliced, giving rise to two isoforms that differ by a 6-amino acid insertion at the start of the seventh repeat. Annexin VI has been implicated in mediating the endosome aggregation and vesicle fusion in secreting epithelia during exocytosis.
仅用于科研。不用于诊断过程。未经明确授权不得转售。
生物信息学
蛋白别名: 67 kDa calelectrin; Annexin A6; Annexin VI; annexin VI (p68); annexin VI, p68; Annexin-6; calcium-binding protein 65/67; calcium-binding protein CATA 65/67; calcium-binding protein p68; calelectrin; calphobindin II; Calphobindin-II; CBP 65/67; Chromobindin-20; CPB-II; Lipocortin VI; p68; p70; Protein III; testis secretory sperm-binding protein Li 198a
基因别名: ANX6; ANXA6; AnxVI; AW107198; Cabm; Camb; CBP68; CPB-II
UniProt ID: (Human) P08133, (Mouse) P14824
Entrez Gene ID: (Human) 309, (Mouse) 11749, (Rat) 79125